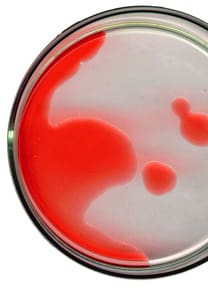

GAY MASS MURDER SUSPECT HELD
GAY MASS MURDER SUSPECT HELD
POLAND URGED TO SIGN RIGHTS CHARTER

POLAND URGED TO SIGN RIGHTS CHARTER
THE SWEET CYNICISM OF JAY BRENNAN

THE SWEET CYNICISM OF JAY BRENNAN
SEARCH FOR THE ELUSIVE VACCINE
SEARCH FOR THE ELUSIVE VACCINE
AIDS AND HUMAN RIGHTS INSEPARABLE

AIDS AND HUMAN RIGHTS INSEPARABLE